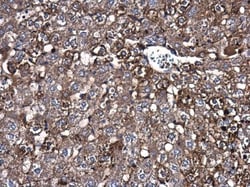
Invitrogen Caspase 3 Polyclonal Antibody 100 &mu;L; Unconjugated:Antibodies,

Learn More
Invitrogen™ Caspase 3 Polyclonal Antibody


Rabbit Polyclonal Antibody
Brand: Invitrogen™ PA577887
Description
Positive Control: HeLa, HeLa (30 μM Cisplatin treatment for 24 hr), PC-12 (30uM cisplatin treatment for 24h), PC-12, Rat2, C8D30, NIH-3T3, Raw264.7, C2C12, Jurkat, Raji, NCI-H929, K562, THP-1, HL-60 Predicted Reactivity: Dog (89%), Cat (87%), Pig (88%), Rabbit (86%), Chimpanzee (99%), Bovine (84%) Store product as a concentrated solution. Centrifuge briefly prior to opening the vial.
This gene encodes a protein which is a member of the cysteine-aspartic acid protease (caspase) family. Sequential activation of caspases plays a central role in the execution-phase of cell apoptosis. Caspases exist as inactive proenzymes which undergo proteolytic processing at conserved aspartic residues to produce two subunits, large and small, that dimerize to form the active enzyme. This protein cleaves and activates caspases 6, 7 and 9, and the protein itself is processed by caspases 8, 9 and 10. It is the predominant caspase involved in the cleavage of amyloid-beta 4A precursor protein, which is associated with neuronal death in Alzheimer's disease. Alternative splicing of this gene results in two transcript variants that encode the same protein.
Specifications
| Caspase 3 | |
| Polyclonal | |
| Unconjugated | |
| CASP3 | |
| A830040C14Rik; AC-3; Apopain; Apopain precursor; Casp3; CASP-3; caspase 3; Caspase 3 apoptosis related cysteine protease (ICE-like cysteine protease); caspase 3, apoptosis related cysteine protease; Caspase 3, apoptosis related cysteine protease (ICE-like cysteine protease); caspase 3, apoptosis-related cysteine peptidase; caspase 3, apoptosis-related cysteine protease; Caspase3; caspase-3; Caspase-3 subunit p12; Caspase-3 subunit p17; Caspase-3-like protein; CC3; Cpp32; CPP-32; CPP32B; CPP32beta; cysteine protease CPP32; cysteine protease; CPP32; apopain; ICE3; IRP; LICE; mldy; PARP cleavage protease; procaspase3; protein Yama; SCA-1; SREBP cleavage activity 1; Yama; yama protein | |
| Rabbit | |
| Antigen affinity chromatography | |
| RUO | |
| 12367, 25402, 836 | |
| Store at 4°C short term. For long term storage, store at -20°C, avoiding freeze/thaw cycles. | |
| Liquid |
| Dot Blot, Immunohistochemistry (Frozen), Immunohistochemistry (Paraffin), Immunoprecipitation, Western Blot, Immunocytochemistry | |
| 0.15 mg/mL | |
| PBS with 20% glycerol, 1% BSA and 0.025% ProClin 300, pH 7 | |
| P42574, P55213, P70677 | |
| CASP3 | |
| Recombinant protein encompassing a sequence within the center region of human Caspase 3. The exact sequence is proprietary. | |
| 100 μL | |
| Primary | |
| Human, Mouse, Rat | |
| Antibody | |
| IgG |
Your input is important to us. Please complete this form to provide feedback related to the content on this product.